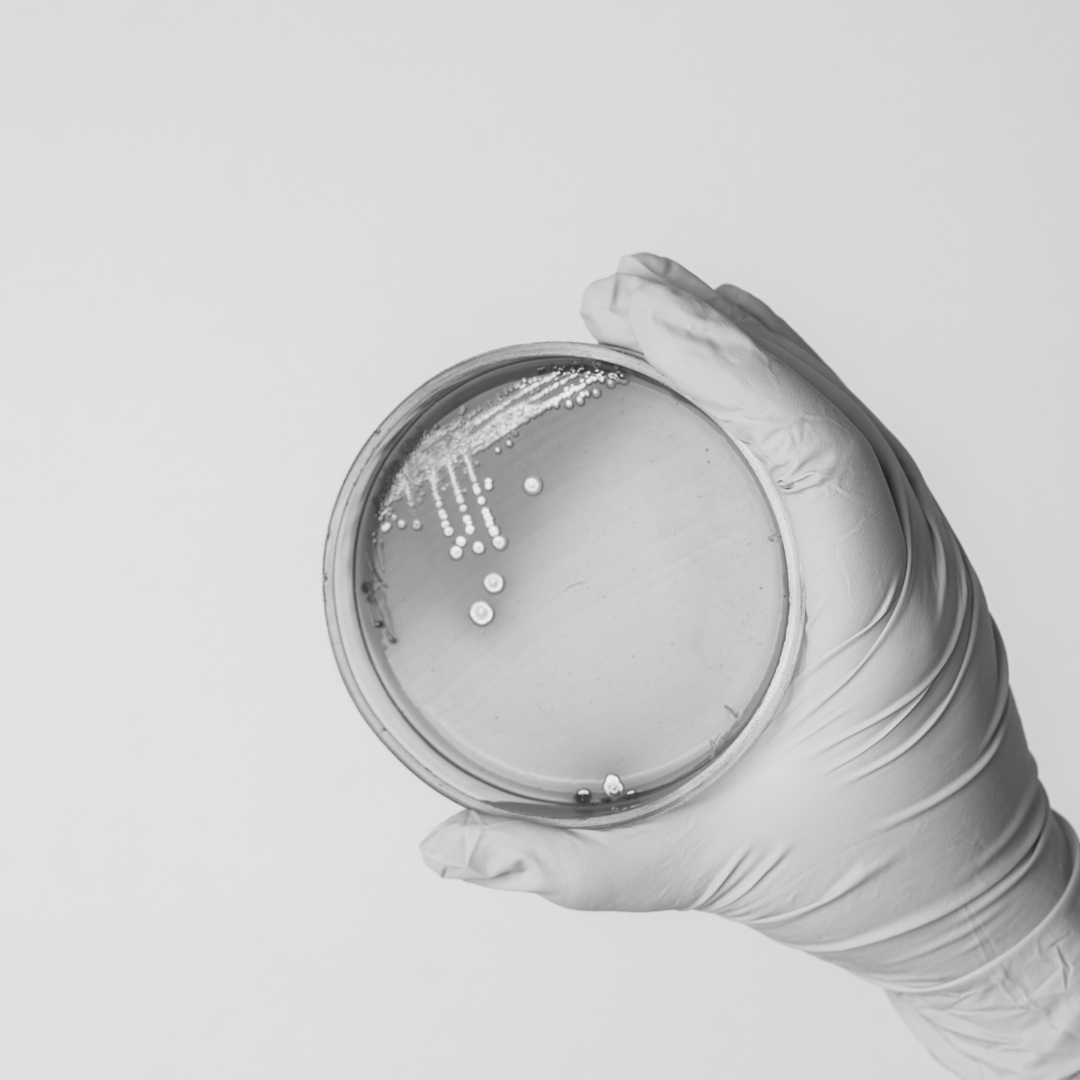

The beauty of fermentation
Our story

Practiced for thousands of years by every culture, fermentation connects us all,
an ancient blend of science, heritage, & tradition.
We are Ethos & Co
a cultured journey
Teaming up with an artisan producer of fermented coconut oil in Cambodia sparked Ethos founder Hana's interest in probiotics as the future of skincare.
Having experienced the wellness power of probiotics in her own health journey, she realised its potential to transform skin health as well.
Over the last three years she's done a deep dive into skin microbiome science and probiotics for better skin health, applying knowledge from her healthcare degree, & scientifically validating the coconut oil's living probiotics.
Together with husband Gerard, she's built an evidence-led brand that cares for the skin from the microbiome up, combining nature's blueprint, the latest science, and local tradition.


reimagining skincare
learning from nature
With a shared obsession for nature growing up in Aotearoa/New Zealand, the natural world is the foundation of Ethos skincare, for Hana & Gerard.
Through their vision to make the invisible world of the skin visible, they have embraced a new era of radically different skincare that works synergistically with the skin's natural ecosystem. Their biome-based skincare is designed to address the rise in skin conditions associated with microbiome imbalance, harnessing the natural tool of fermentation to build balance back into the skin ecosystem and create bioactives for skin healing & regeneration.

Find us on Instagram